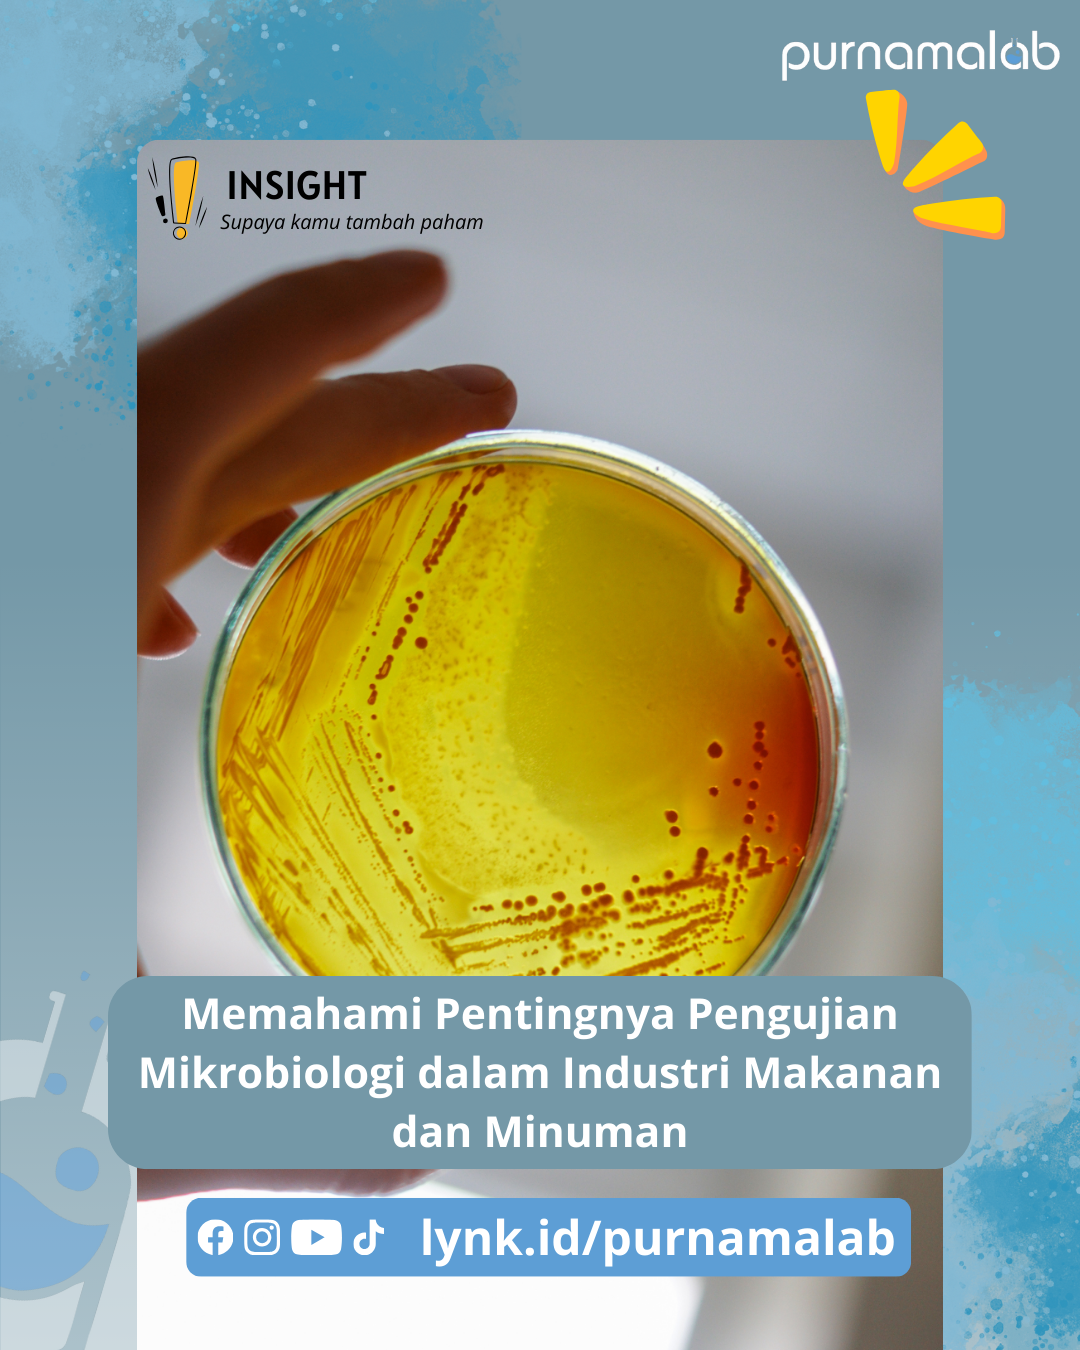

Purnamalab News Update
Memahami Pentingnya Pengujian Mikrobiologi dalam Industri Makanan dan Minuman
April 10th, 2025
Dalam industri makanan dan minuman, keamanan dan kualitas produk adalah prioritas utama. Salah satu langkah krusial untuk memastikan hal ini adalah melalui pengujian mikrobiologi yang komprehensif. Pengujian ini tidak hanya mendeteksi keberadaan mikroorganisme berbahaya seperti bakteri, jamur, dan virus, tetapi juga memastikan bahwa produk yang dihasilkan memenuhi standar kesehatan dan keamanan yang ketat.
Mengapa Pengujian Mikrobiologi Penting?
Keamanan Konsumen: Mencegah penyakit bawaan makanan yang disebabkan oleh kontaminasi mikroba.
Kualitas Produk: Memastikan produk tetap segar, tahan lama, dan memiliki kualitas yang konsisten.
Kepatuhan Regulasi: Memenuhi persyaratan hukum dan standar industri yang berlaku.
Reputasi Merek: Membangun kepercayaan konsumen terhadap merek Anda.
Layanan Unggulan Purnamalab.com
Purnamalab.com hadir sebagai mitra terpercaya bagi industri makanan dan minuman dalam menyediakan layanan pengujian mikrobiologi yang akurat dan terpercaya. Dengan tim ahli yang berpengalaman dan peralatan laboratorium yang canggih, kami menawarkan berbagai layanan pengujian, termasuk:
Analisis bakteri patogen (Salmonella, E. coli, dll.)
Pengujian jamur dan kapang
Analisis total plate count (TPC)
Pengujian sterilitas
dan masih banyak lagi
Kami memahami bahwa setiap bisnis memiliki kebutuhan yang unik. Oleh karena itu, kami menyediakan solusi pengujian yang disesuaikan dengan kebutuhan spesifik Anda. Dengan Purnamalab.com, Anda dapat memastikan bahwa produk Anda aman, berkualitas, dan memenuhi standar tertinggi.
Hubungi Kami Hari Ini!
Jangan kompromikan keamanan dan kualitas produk Anda. Kunjungi purnamalab.com untuk informasi lebih lanjut tentang layanan pengujian mikrobiologi kami. Kami siap membantu Anda menjaga standar kualitas tertinggi dalam industri makanan dan minuman.
Berita & Gallery Berkaitan

PT Purnama Laboratory Akan Berpartisipasi dalam Pameran Indowater 2026
PT Purnama Laboratory kembali hadir dalam salah satu pameran industri air terbesar di...

PT Purnama Laboratory Resmi Menjadi Authorized Distributor untuk Wiggens, Joanlab, dan HuanKai Microbial
PT Purnama Laboratory terus memperluas portofolio solusi laboratoriumnya untuk memenuhi...

Webinar Nasional Food Safety 2026 – Penguatan Keamanan Pangan Segar untuk Mendukung Program Makan Bergizi Gratis
Ikuti Webinar Nasional Food Safety 2026 yang diselenggarakan oleh Purnamalab dengan...


